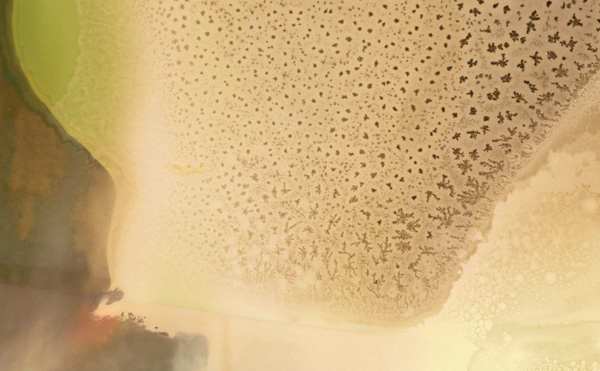

“Writing about photographs is a risk. The first sign of a good photograph is that it makes you want to say something about it. The second sign is that it makes whatever you say seem inadequate. The best photographs entice commentary then demean it, stimulating reaction and then cutting it off, producing noise only to extinguish it. The image actively silences the viewer.”—Mark Wrigley